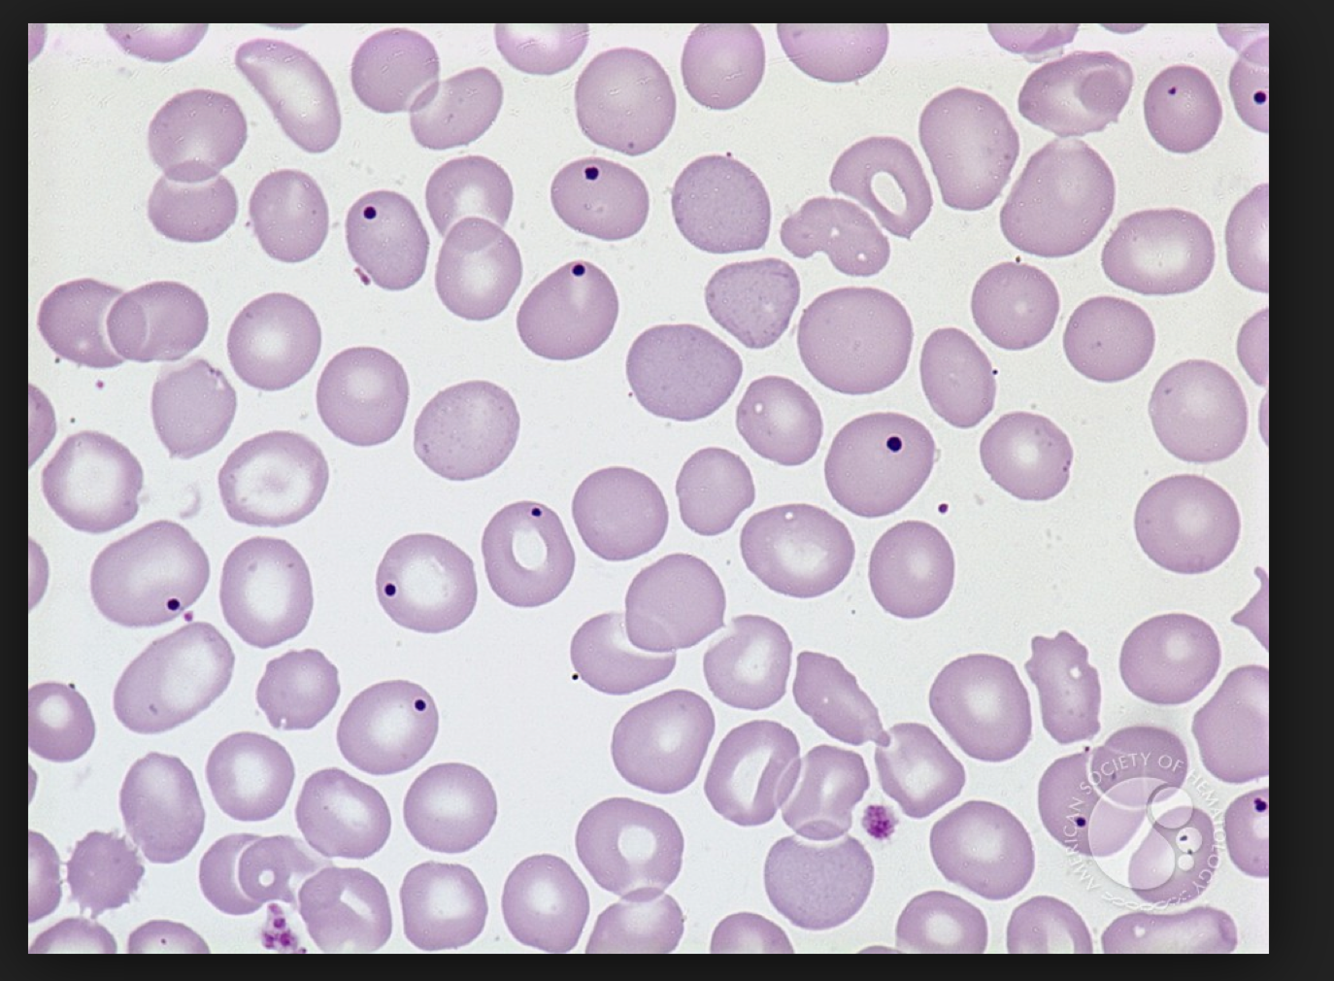
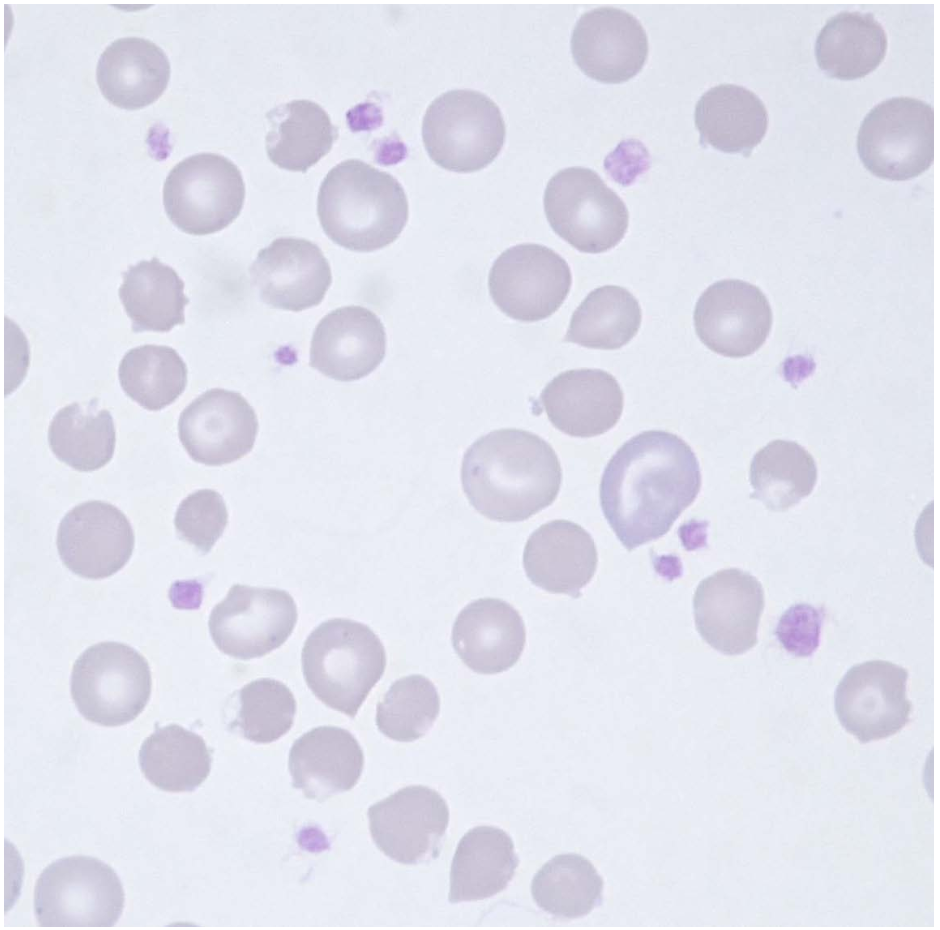
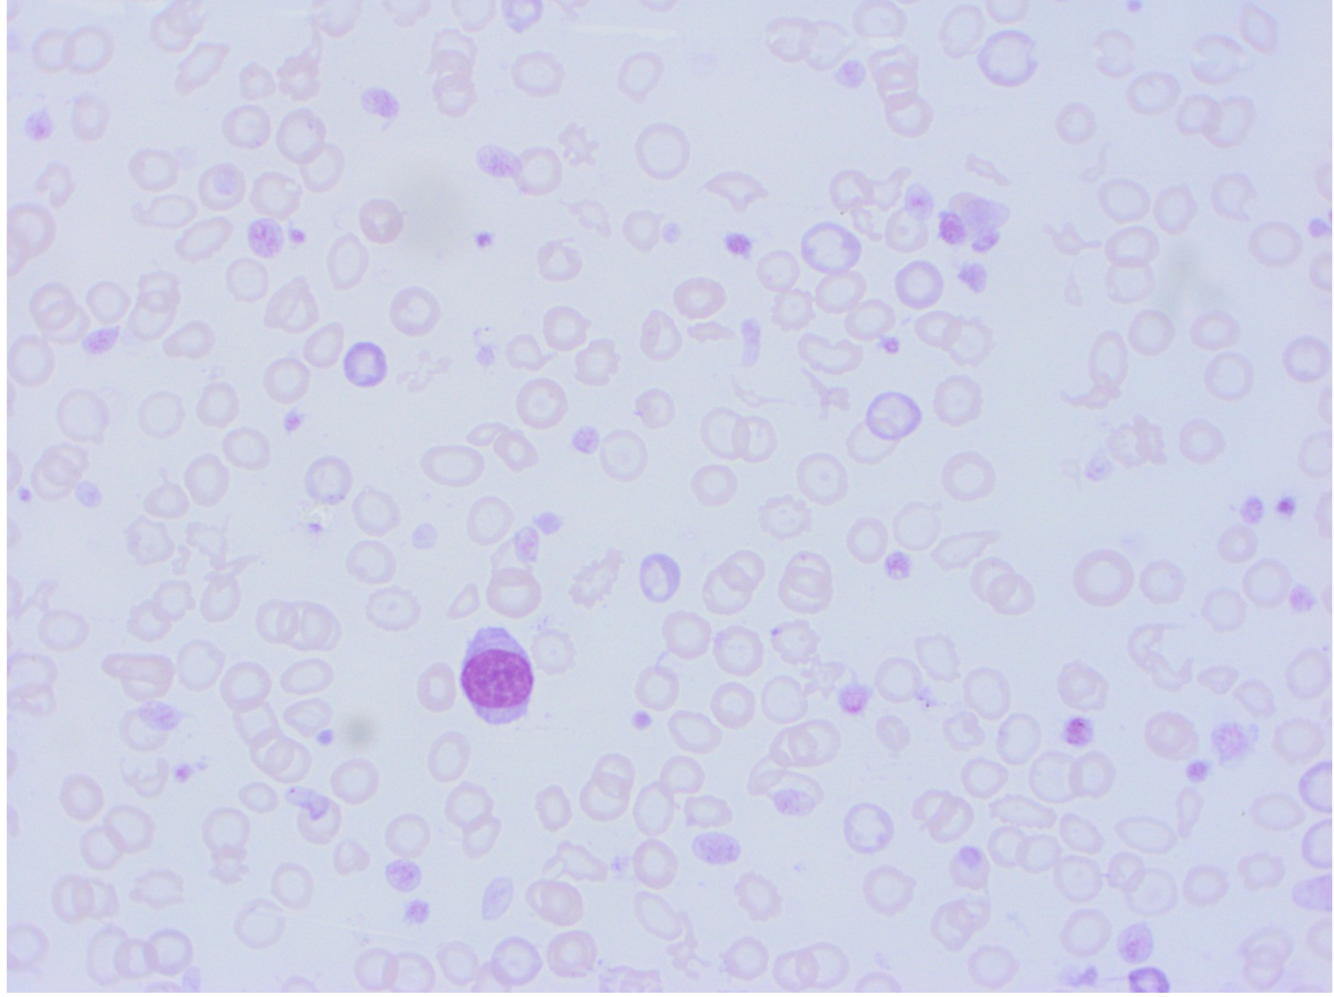

Feline platelets appear to aggregate (clump) more readily than other species. If platelet clumps have formed during blood sampling, they can be best appreciated while examining the feathered edge. Why is this finding important to recognize in all species, not just cats?
Have to consider DIC, sequestration, or lack of production by the bone marrow
* Anything about 100 is adequate for clotting anyway
Note the morphology of feline erythrocytes- how do they compare to canine erythrocytes? e.g. size shape colour central pallor inclusions
canine- relatively large, uniform, biconcave disc
feline- not as uniform, smaller, no central pallor, Hb of cats is more susceptible to oxidant injury, low numbers of Heinz bodies can be seen in normal cats
What disease process does the presence of these atypical cells most likely indicate?
Neoplasia
How is the presence of agglutination likely to affect the RCC? Would this affect any of the calculated indices?
False low reading, false readings on MCV MCH MCHC
* If the RCC is wrong, the other readings would be incorrect as well

Polychromatophil are our reticulocytes
And no arrow- Heinz Bodies (points to oxidative damage)
Howell Jolly Bodies
Sign of regenerative anaemia, if we have a lot of them then we think about the marrow– dyserythropoeisis
* random ones no problem

Basophilic stippling
* Lead poisoning
* In ruminants, basophilic stippling is common and has the same significance as polychromasia
Dark stool in a dog DDX
Ulcers in the gastrointestinal system
Tumors of the esophagus or stomach
Infections
Foreign body in the gastrointestinal system
Disorders involving inflammation of the intestinal system
Kidney failure
Drug toxicity (e.g., anticoagulant drugs)
Diet containing raw food
Pneumonia
Trauma
Disorders involving abnormal clotting of blood
Causes of thrombocytosis
Haemhorrage
Excitement- splenic contraction
Neoplasia
- especially Hepatic carcinoma, malignant histiocytosis, lymphoma, mast cell tumor
Inflammation - e.g. Lymphocytic-plasmacytic enteritis
Hyperadrenocorticism
Immune-mediated hemolytic anemia
Chronic allergies
Iatrogenic - glucocorticoids, vincristine
Most likely mechanism for hypocalcaemia given the results?

Hypoalbuminaemia
What is pica?
Eating strange things- could mean vitamin deficiency
* Platelet clumping- spurious thrombocytopaenia, common in cats as an artefact (EDTA)
* atypical cells in the feathered edge- round nucleus, cytoplasm packed with dark granules– MAST CELLS (other ddx is basophil– in cats lavender granules)
* Howell Jolly body- normal for occasional sitings in cats

MCT in the spleen
* Histamine release–> gastic ulceration
6 yo MN Standard Poodle
Hx: Acute onset of severe exercise intolerance
PE: Temp: 39.7 C RR 56. Pale and icteric mucous membranes. Enlarged spleen and liver.
* Very high WCC because of the NRBC– but still massive leukocytosis not uncommon in haemolytic anaemia
* Ghost cells, spherocytes
* Marked neutrophilia with regenerative left shift
* Severe inflammation but not so severe that the marrow has become depleted
* Marked monocytosis because they are eating red cells– increasing in number to migrate into the different organs

IMHA
* Enlarged liver and spleen due to attempt to produce haematopoietic cells in the spleen and liver just like they did when they were young (also microthrombi causing liver damage– swelling because of liver necrosis)
* Haemolytic regenerative anaemia– causes massive inflammation
* Microthrombi often occurs–> causes areas of necrosis in lots of organs particularly liver and kidney– often also a profound leukocytosis (inflammation) AND haemolysis due to the excess free haemoglobin
2 yo neutered female Pug
Acute weakness, lethargy, and inappetance
PE: pale MM, passed reddish urine in consult room
* astericks mean something isn’t right according to the analyzer
* Dipstick from urine- positive for blood (not myoglobin)
* Thrombocytosis– due to the inflammation (though you can see thrombocytopaenia), chronic haemorrhage, splenic contraction (in response to hypoxia, anaemia)

Due to eccentrocytes and Heinz Bodies with everything else–> oxidative damage–> THEREFORE ONION TOXICITY
* Regenerative anaemia normocytic– is there haemorrhage or haemolysis?
When do you see a falsely high MCHC?
Free haemoglobin (haemolysis), lipaemia interferes with measurement of haemoglobin, Heinz bodies intefere with measurement of Hb as well
MCHC can’t truly be increased
Eccentrocytes
Heinz Bodies (sticking out noses)- damaged Hb sticking out
8 yo neutered male Staffy
Chronic lethargy, pica, dark faeces
pale mucous membranes, otherwise NAD
Microcytic, hypochromic = iron deficient (or breed specific with low MCVs e.g. Chowchow)

Bleeding from gastrointesintal tract causing iron deficiency– if it was internal it would recycle
Bleeding tumour, chronic intussusception that is not fully blocking
Activated lymphocyte
Schistocytes
Hypochromic
Acanthocytes
Echinocytes
(IRON DEFICIENCY)
What is cytology? Advantages and disadvantages?

How do you enhance cytological interpretation? Best diagnostic information by??

Equipment required for cytology

Systemic approach to cytology

5 main differentials with round cells seen in cytology


What is a carcinoma- what kind of cell? How do they go with cytology?







































































































































































































































































